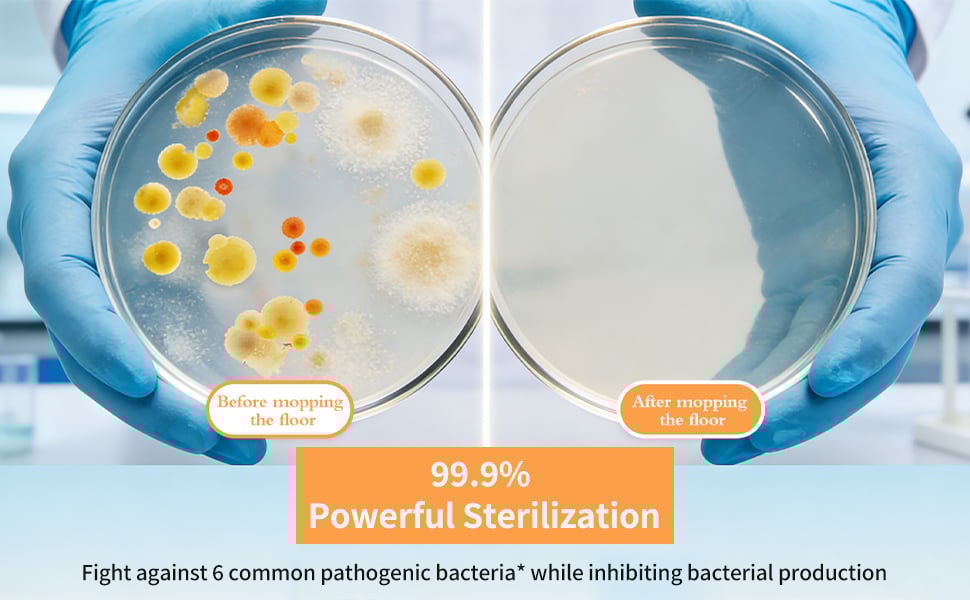
SOPAMI floor cleaning tablets

🎁Just $7 each🎁Floor Cleaning Tablets - Safe for Wood Tile Marble Quick Dry No Residue
❤️TIPS: Our goods are authentic, made of USA, with genuine patents, counterfeit must be investigated! Customers please identify our products!

✈️SHIPPING WORLDWIDE.
💯Payments Via PayPal® and CreditCard.
⭐Fast refund Guarantee>> Partial or full refund depends on the situation.
📞 Tracking Number for Every Order
✨Skip the mess, the weight, and the damage of traditional floor cleaners. This Floor Cleaning Tablets give you powerful deep cleaning, long-lasting freshness, and zero-residue shine — all in one tiny, convenient tablet.

🧱 Safe for Wood, Tile & Marble Surfaces
Specially formulated to be gentle on all floor types, including wood, tile, and marble. It cleans effectively without scratching, fading, or damaging expensive flooring, giving you full confidence with every mop.

💨 Quick Dry & Zero Streak Residue
The advanced formula dries quickly with no streaks, film, or sticky residue. You get shiny, clean floors you can walk on right away — no waiting, no smudges, no hassle.

🧪 Oxygen-Powered Deep Cleaning Action
Powered by active oxygen molecules, the tablets penetrate deep into grout and tile pores to dissolve tough grease, dirt, and even stubborn pet stains. It removes 99.9% of grime ordinary cleaners leave behind.
🍋 48-Hour Fresh Lemon Scent
Using microencapsulated fragrance technology, this cleaner releases a light, pleasant lemon aroma that lasts up to 48 hours after mopping, keeping your home naturally fresh all day long.

⚡ Ultra-Fast Dissolving Convenience
Each tablet dissolves completely in just 30 seconds — simply drop one into 500ml of water for a ready-to-use cleaning solution. Lightweight, compact, and eliminates bulky plastic cleaner bottles.

🎯 Who These Floor Cleaning Tablets Are For
- Busy families who want quick, easy mopping every day
- Pet owners struggling with stains, odors, and footprints
- Homes with wood, tile, marble, or multi-surface flooring
- Anyone who hates streaks, residue, and heavy cleaning bottles
- Eco-friendly users looking for safer, cleaner household products

OUR GUARANTEE
📦 Insured Worldwide Shipping: Each order includes real-time tracking details and insurance coverage in the unlikely event that a package gets lost or stolen in transit.
💰 Money-Back Guarantee: If your items arrive damaged or become defective within 15 days of normal usage, we will gladly issue out a replacement or refund.
✉️ 24/7 Customer Support: We have a team of live reps ready to help and answer any questions you have within a 24-hour time frame, 7 days a week.
🔒 Safe & Secure Checkouts: We use state-of-the-art SSL Secure encryption to keep your personal and financial information 100% protected.








